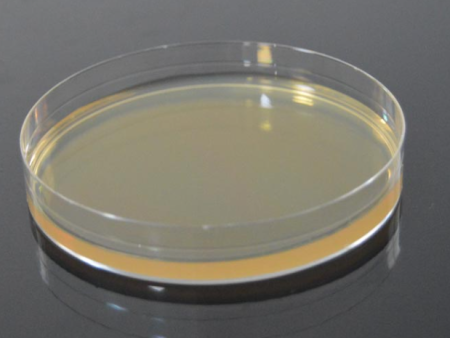

培養(yǎng)基
| 聯(lián)系人: | 陳經(jīng)理 |
|---|---|
| 手機: | 18934727310 |
| 座機: | 0771-5330368 / 5307368 |
| QQ: | 3001673956 / 3001664790 / 3001645900 / 3001641208 |
| 網(wǎng)站: | www.utppsa.com |
| 地址: | 中國(廣西)自由貿(mào)易試驗區(qū)南寧片區(qū)云英路8號五象總部大廈B座6樓 |
| 留言咨詢 更多信息 | |
| 分享: |

|
產(chǎn)品介紹
SS瓊脂BR250g
MRS瓊脂(MRSA)250g
瓊脂粉BR250g
瓊脂粉250g
瓊脂條BR250g
瓊脂條BR100g
瓊脂糖BR10g
營養(yǎng)瓊脂(GB)BR250g
營養(yǎng)瓊脂250g
營養(yǎng)瓊脂培養(yǎng)基250g
營養(yǎng)瓊脂(NA國標)250g
營養(yǎng)瓊脂BR250g
營養(yǎng)肉湯250g
營養(yǎng)肉湯培養(yǎng)基(NB) BR250g
營養(yǎng)肉湯(GB)BR250g
蛋白胨BR250g
細菌學蛋白胨BR400g
胰蛋白胨BR250g
胰蛋白胨(胰酪胨)BR400g
胰蛋白胨500g
胰蛋白胨1.05459.0500
酪蛋白胨250g
大豆蛋白胨BR200g
大豆蛋白胨BR250g
大豆蛋白胨BR400g
示蛋白胨250g
緩沖蛋白胨水250g
緩沖蛋白胨水(BR)250g
乳糖蛋白胨培養(yǎng)液250g
乳糖蛋白胨培養(yǎng)液BR250g
牛肉浸膏BR500g
牛肉浸膏500g
牛肉浸粉BR250g
酵母浸膏BR500g
酵母浸粉250g
EC肉湯250g
EC肉湯BR250g
LB肉湯BR250g
MFC培養(yǎng)基BR250g
MFC培養(yǎng)基BR100g
EC-MUG培養(yǎng)基100g
三糖鐵瓊脂250g
3.5%氯化鈉三糖鐵瓊脂250g
三糖鐵瓊脂培養(yǎng)基(TSI)BR250g
麥康凱瓊脂250g
麥康凱瓊脂培養(yǎng)基BR250g
玫瑰紅鈉瓊脂250g
玫瑰紅鈉瓊脂培養(yǎng)基BR250g
沙氏葡萄糖瓊脂培養(yǎng)基250g
沙氏瓊脂培養(yǎng)基BR250g
液體沙氏培養(yǎng)基250g
膽鹽乳糖發(fā)酵培養(yǎng)基BR250g
乳糖膽鹽發(fā)酵培養(yǎng)基BR250g
乳糖膽鹽發(fā)酵培養(yǎng)基250g
乳糖膽鹽發(fā)酵培養(yǎng)基BR250g
乳糖膽鹽培養(yǎng)基BR250g
膽鹽乳糖增菌液(膽鹽乳糖培養(yǎng)基)250g
膽鹽乳糖增菌液BR250g
膽鹽乳糖培養(yǎng)基BR250g
乳糖復(fù)發(fā)酵(乳糖發(fā)酵)培養(yǎng)基250g
乳糖發(fā)酵 (乳糖復(fù)發(fā)酵)培養(yǎng)基BR250g
乳糖復(fù)發(fā)酵(乳糖發(fā)酵)培養(yǎng)基250g
5%乳糖發(fā)酵培養(yǎng)基BR100g(杭州)
GN增菌液培養(yǎng)基BR250g
GN增菌培養(yǎng)基BR250g
GN增菌液BR250g
7.5%氯化鈉肉湯培養(yǎng)基BR250g
3%氯化鈉堿性蛋白胨水(APW)250g
葡萄糖肉浸液肉湯BR250g
葡萄糖肉浸液肉湯250g
雙料乳糖膽鹽胨水BR250g
霉菌培養(yǎng)基(真菌培養(yǎng)基)250g
血液瓊脂基礎(chǔ)250g
卵磷脂.吐溫80營養(yǎng)瓊脂250g
平板計數(shù)瓊脂250g
伊紅美蘭瓊脂BR250g
伊紅美藍瓊脂培養(yǎng)基(EMB)BR250g
虎紅瓊脂2#下 BR250g
孟加拉紅培養(yǎng)基BR250g
改良MC培養(yǎng)基250g
孟加拉紅培養(yǎng)基BR500g
克氏雙糖鐵瓊脂BR250g
亞硫酸鉍瓊脂培養(yǎng)基250g
亞硫酸鉍瓊脂培養(yǎng)基100g
膽硫乳瓊脂培養(yǎng)基(DHL)250g
品紅亞硫酸鈉瓊脂250g
胰蛋白胨大豆肉湯250g
胰蛋白胨大豆肉湯培養(yǎng)基(TSB)BR250g
高鹽察氏瓊脂250g
高鹽察氏瓊脂培養(yǎng)基BR250g
葡萄糖蛋白胨培養(yǎng)基250g
十六烷三甲基溴化銨瓊脂250g
十六烷三甲基溴化銨瓊脂100g
溴化十六烷基三甲銨瓊脂培養(yǎng)基250g
SCDLP液體培養(yǎng)基250g
BAird-Parker培養(yǎng)基250g
瓊脂基礎(chǔ)BR250g(BP)
MHA瓊脂(水解酪蛋白瓊脂)250g
亞硒酸鹽胱氨酸增菌液培養(yǎng)基250g
亞硒酸鹽胱氨酸增菌液(SC)BR100g
亞碲酸鉀卵黃增菌液5ml
厭氧發(fā)生片(3.5升厭氧產(chǎn)氣袋
厭氧罐專用接口
四硫磺酸鈉煌綠增菌液培養(yǎng)基BR250g
四硫磺酸鹽煌綠增菌液培養(yǎng)基BR100g
煌綠乳糖膽鹽肉湯(BGLB)BR250g
四硫磺酸鈉煌綠增菌液(TTB)BR250g
煌綠乳糖膽鹽肉湯(BGLB)BR250g
四硫磺酸鈉煌綠增菌液基礎(chǔ)BR250g
賴氨酸脫羧酶培養(yǎng)基(LD)5g
賴氨酸脫羧酶生化管
馬鈴薯葡萄糖瓊脂250g
馬鈴薯葡萄糖瓊脂(PDA)BR250g
志賀氏沙門增菌液250g
平板計數(shù)培養(yǎng)基250g
平板計數(shù)瓊脂培養(yǎng)基(含糖瓊脂PCA)BR250g
平板計數(shù)瓊脂BR250g
曙紅亞甲基藍瓊脂培養(yǎng)基BR250g
改良馬丁培養(yǎng)基250g
改良馬丁液體培養(yǎng)基(真菌培養(yǎng)基)BR250g
改良馬丁液體培養(yǎng)基BR250g
改良馬丁培養(yǎng)基250g
改良馬丁瓊脂250g
麥芽汁培養(yǎng)基250g
麥芽浸膏湯BR250g
兔血漿(凍干血漿)0.5ml
血平板(普通)90mm(
血平板70mm
OXA瓊脂平板(牛津瓊脂平板)90mm
哥倫比亞 血平板90mm
溴甲酚紫葡萄糖肉湯250g
氧化酶試劑
氨基酸脫酸酶對照
氨基酸脫羧酶試驗培養(yǎng)基礎(chǔ)100g
半固體營養(yǎng)瓊脂250g
半固體動力培養(yǎng)基250g
0.5% 葡 萄 糖 肉 湯 ( 肉 湯 培 養(yǎng) 基)BR250g
HE瓊脂100g
HE瓊脂250g
綠膿菌素測定培養(yǎng)基250g
TCBS瓊脂250g(陸橋)
TCBS瓊脂BR250g
菌落總數(shù)紙片
纖維素酶BR1g
過氧化物酶(辣根)RZ-3 BR100mg
氯化鎂孔雀綠肉湯250g
WS瓊脂BR250g
尿素瓊脂基礎(chǔ)培養(yǎng)基250g
***胺蘭-DNA瓊脂 50g
B-半乳糖苷ONPG
丙二酸鹽培養(yǎng)基10g
蛋白胨水(靛基質(zhì)培養(yǎng)基)100g
氯化鈉結(jié)晶紫增菌液250g
氯化鈉蔗糖瓊脂250g
靛基質(zhì)試劑10ml
蛋白胨水(靛基質(zhì)試劑)
Kovacs靛基質(zhì)試劑10ml
木糖賴氨酸脫氧膽鹽瓊脂(XLD)250g
結(jié)晶紫中性紅膽鹽瓊脂(VRBA)250g
乳糖肉湯250g
緩沖蛋白胨水培養(yǎng)基250g
硫乙醇酸鹽液體硫體培養(yǎng)基250g
緩沖葡萄糖蛋白胨水培養(yǎng)基250g
硫乙醇酸鹽液體培養(yǎng)基(FT)BR250g
硫乙醇酸鹽流體培養(yǎng)基250g
結(jié)晶紫中性紅膽鹽瓊脂(VRBA)250g
葡萄狀球菌選擇性瓊脂250g
葡萄球菌生化鑒定管
***檢定培養(yǎng)基Ⅱ號6.6 250g
***檢定培養(yǎng)基Ⅰ號(低PH)250g
***檢定培養(yǎng)基Ⅰ號(高PH)250g
***檢定培養(yǎng)基Ⅱ號(低PH)250g
***檢定培養(yǎng)基Ⅱ號(高PH)250g
UBA培養(yǎng)基250g
V-P甲乙液10ml
甲基紅試劑MR10ml
沙門氏菌屬Vi因子診斷***1ml
沙門氏菌屬診斷***11種
TTC營養(yǎng)瓊脂
TTC瓊脂 BR500g
月桂基硫酸鹽胰蛋白胨肉湯BR250g
月桂基胰蛋白胨肉湯500g
西蒙氏枸櫞酸鹽瓊脂250g
糖發(fā)酵基礎(chǔ)肉湯BR250g
MR-VP培養(yǎng)基250g
皰肉牛肉粒100g
豆粉瓊脂250g
木糖(木膠糖)
乳糖
D-麥芽糖
D-蕈糖(海藻糖)
半乳糖
衛(wèi)茅醇(甜醇)
山梨醇
磷酸鹽葡萄糖胨水培養(yǎng)基250g
葡萄糖半固體培養(yǎng)基250g
葡萄糖半固體生化管
肉浸液肉湯培養(yǎng)基250g
肉浸液肉湯250g
水楊素(水楊苷)
***
尿素
亮綠乳糖培養(yǎng)基250g
沙門氏顯色培養(yǎng)基1000ml
弧菌顯色培養(yǎng)基100ml
我妻氏培養(yǎng)基基礎(chǔ)250g
酵母葡萄糖***瓊脂(YDC)250g
改良的Mc Bride瓊脂(MMA)250g
LB瓊脂BR250g
硝酸鹽蛋白胨水培養(yǎng)基250g
硝酸鹽胨水培養(yǎng)基250g
規(guī)格
匹克氏肉湯基礎(chǔ)100g
血瓊脂基礎(chǔ)250g
腦心浸出液肉湯(BHI)250g
MRS肉湯(MRS)250g
血瓊脂培養(yǎng)基基礎(chǔ)250g
氏檸檬酸鹽肉湯100g
40%尿素水
BBL瓊脂培養(yǎng)基基礎(chǔ)250g
皰肉培養(yǎng)基基礎(chǔ)250g
七葉苷培養(yǎng)基10g
乳酸桿菌肉湯培養(yǎng)基250g